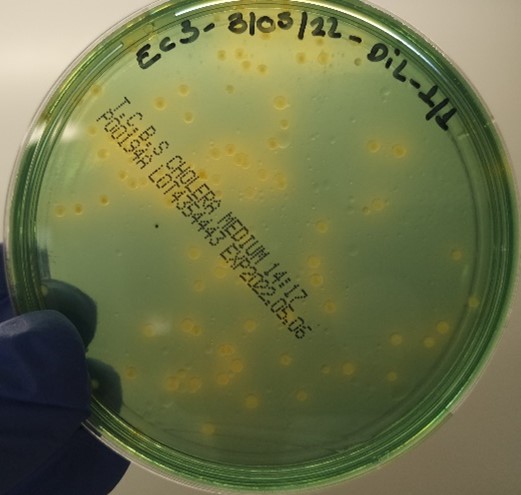
Image module

Notre accompagnement
Mise en place d’essais terrain grâce à nos partenariats avec des fermes d’eau douce et marines.
Conception de protocoles techniques, études scientifiques et de marché sur un sujet spécifique, soutien scientifique pour le diagnostic de maladies émergentes.
Mise en place d’essai(s), conception du protocole(s), échantillonnage(s), suivi, rédaction de rapports (scientifiques/commerciaux/industriels).